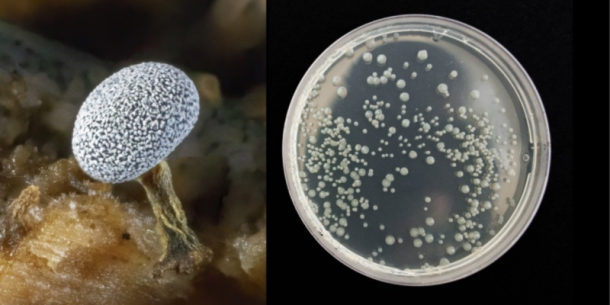
Tipificación Molecular Fúngica

Café “cold brew” y RTD: seguridad microbiológica, vida útil y validaciones para 2025
El auge del cold brew y de las bebidas listas para tomar (RTD) abrió oportunidades y también desafíos de inocuidad. A diferencia de un café caliente, el cold brew se extrae a temperatura ambiente o refrigerada y suele…
Erick Sabino
Determinación de Vitamina D2 en pan de caja
¿Qué es la Vitamina D2?
Es una vitamina que se encuentra en alimentos de origen vegetal. También se le conoce como ergocalciferol. Es producida por…
Rodrigo García
¿Miel fraudulenta? Una revisión sobre la adulteración de la miel y los métodos analíticos para su detección.
La miel es un alimento natural producido por las abejas, que ha sido utilizado por la humanidad durante siglos como alimento y como medicina. Sin emb…
Luis Diego Umaña
Nuevas tendencias alimentarias: Oportunidades para los Productores Centroamericanos
La industria alimentaria está en constante evolución, cada año surgen nuevas tendencias que cambian la forma en que consumimos y pensamos sobre los a…
Daniel Cordero
Seguridad alimentaria: Adulteración del alcohol
¿Qué es la adulteración del alcohol?
Consiste en la producción fraudulenta de bebidas alcohólicas a partir de la sustitución de etanol como materia…
Kaslyn Lopez
Análisis de extraíbles y lixiviables en dispositivos médicos
Análisis de extraíbles y lixiviables
En primer lugar, el análisis de extraíbles y de lixiviables consiste en la determinación de aquellas sustancias…
Deyne Marca
Contaminantes y residuos en productos cárnicos
En la gestión pasada la industria mundial de la carne de res alcanzó los USD 332 280 millones. En los próximos 5 años se espera que alcance los USD 4…
Sharon Rodriguez
Reciclabilidad de Envases
El consumo excesivo de envases se convirtió en un problema a nivel mundial. Esto porque no se han utilizado de manera eficiente y responsable. Lo que…
Sandra R Benitez
Las xantofilas, uno de los pigmentos responsables de hacer que las proteínas animales se vean más apetitosas.
¿Qué son?
Las xantofilas son un tipo de pigmento responsable de dar color amarillo a las plantas y a los alimentos de origen animal. Son un tipo de…
Ana Laura Barrantes
Determinación Del Poder Calorífico De Combustibles
Se denominan combustibles a aquellos cuerpos que al combinarse con el oxígeno desprenden calor. La calidad de un combustible viene dada por la cantid…
Jackson Lazo
Coeficiente de variación
La elaboración de alimento balanceado se define como el proceso de unificación de muchos ingredientes para obtener un producto homogéneo que pueda ap…
Edgar Ortiz
Glifosato: cerca de su desaparición
El glifosato es un herbicida ampliamente utilizado en la agricultura para controlar malezas y maximizar la producción de cultivos. Sin embargo, en lo…
Erick Sabino
Tipificación Molecular Fúngica
¿Qué es la tipficación molecular fúngica?
Es la identificación de microorganismos mediante la secuenciación de determinados objetivos moleculares. E…
Eventos
Webinars
-
 ¿Microorganismos que se encuentran en el queso son beneficiosos?
¿Microorganismos que se encuentran en el queso son beneficiosos? -
 Las xantofilas, uno de los pigmentos responsables de hacer que las proteínas animales se vean más apetitosas.
Las xantofilas, uno de los pigmentos responsables de hacer que las proteínas animales se vean más apetitosas. -
 El Sector de Envases y su Vínculo Inquebrantable con la Calidad y las Normativas
El Sector de Envases y su Vínculo Inquebrantable con la Calidad y las Normativas -
 Adulteración en la Industria Apícola
Adulteración en la Industria Apícola -
 Análisis de leches veganas
Análisis de leches veganas -
 Fraudes alimentarios
Fraudes alimentarios